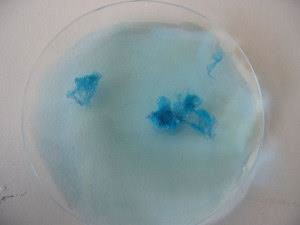

Université DR Moulay Tahar Saida. Dr Belgacem Habiba
Département Des Sciences De la Nature et de La vie
Master 1 Microbiologie Appliquée
TP N° 05 Extraction de l’ADN d’une banane
Il est possible d’extraire de l’ADN à partir d’aliments divers tels que par exemple les petits pois, les bananes ou bien encore les œufs de poisson. Nous utiliserons lors de nos expérimentations de la banane comme matière première.
Matériel & équipement nécessaire par groupe:
|
1/3 Banane (+/- 100 g) |
1 seringues de 10 ml |
|
1 Pissette d’eau distillée |
1 tube à essai + support plasticine |
|
2 pipettes pasteur de 3 ml |
1 pince |
|
Produit vaisselle : 5 ml |
1 passoire |
|
Alcool (Éthanol 95 %) froid : 3 ml |
2 béchers de 250 ml ou de 400 ml |
|
Sel de cuisine : 1 pointe de cuillère (~3 g) |
2 verres de montre |
|
1 Couteau & 1 assiette |
1 cuillère en plastique |
Matériel & équipement pour l’ensemble de la classe
|
1 microscope |
Stock vert de méthyle |
|
1 modèle d’ADN |
Lames & lamelles |
|
|
1. Procédure d’extraction
- Éplucher la banane et la couper en petit morceaux.
- Hacher et mélanger la banane permet de briser et déchiqueter les tissus .
- Mettre les morceaux de banane dans un bécher.
- Ajouter de l’eau distillée dans le bécher, jusqu’au trait de 100 mL.
- Ajouter le sel (une pointe de cuillère ~3g).
- Bien mélanger l’ensemble, en écrasant les morceaux de banane sur la paroi du bécher à l’aide de la cuillère.
- Avec une seringue, ajouter 5 ml de produit vaisselle et mélanger à nouveau.
Les fragments de banane ramollissent progressivement, car le liquide vaisselle dissout les membranes cellulaires et dénature les protéines.
En effet, pour extraire l’ADN, il faut que le noyau sorte de la cellule. Les sels et le savon de vaisselle contenus dans la solution dégradent les
membranes des cellules de banane, la membrane nucléaire du noyau et les protéines qui seraient toujours liées à l’ADN.
- Laisser agir 5 à 10 min.
- Mélanger.
- Filtrer le mélange avec la passoire et récupérer le jus dans le deuxième bécher.
Filtrer le mélange permet de recueillir le liquide riche en ADN et de le séparer des résidus cellulaires et autres tissus.
- Avec une pipette pasteur, prélever 3 ml de jus de banane et les verser dans le tube à essai.
- Avec une autre pipette pasteur, ajouter délicatement 3 ml d’alcool froid en le faisant couler contre la paroi du tube à essai.
Les deux solutions de se mélangent pas et l’alcool forme une couche plus « légère » au-dessus du jus. Pourquoi ?
La masse volumique de l’alcool (éthanol 95% : 0.79) est plus faible que celle de la solution de banane (eau + sel + liquide vaisselle). L’alcool
flotte donc au-dessus du mélange.
- Laissez reposer le tube à essai quelques minutes. Observer.
2. Observations :
Une substance blanche se forme dans l’alcool dans la partie supérieure du tube à essai, on l’appelle la méduse d’ADN. C’est l’ADN de la banane !
L’ADN est insoluble dans l’alcool et précipite donc pour former ce que les biochimistes appellent la « méduse ».
L’ADN forme une double hélice qui présente à l’extérieur des molécules de phosphate et de sucre hydrophiles (qui aime l’eau) et à l’intérieur les
bases A,T,C,G hydrophobes (qui n’aiment pas l’eau). La molécule d’AN est donc soluble dans l’eau et insoluble dans l’alcool où elle précipite.
Est-ce vraiment de l’ADN ?
Comment peut-on montrer que le filament obtenu lors de l’extraction est bien de l’ADN ?
3. Procédure de coloration de l’ADN provenant de l’extraction
Récupérer avec une pince ou une pipette pasteur les filaments blancs précipités dans l’alcool du tube à essai, les placer dans le verre de montre contenant le colorant vert de méthyle , laisser agir 2 min et rincer dans un autre verre de montre contenant de l’eau distillée.
Observations :

Les filaments précipités restent bien colorés après rinçage. Ce que nous avons isolé à partir de la banane est bien de l’ADN !
Dr Belgacem Habiba
